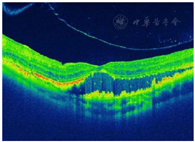

患儿男性,11岁,因"体检发现左眼视力低下1年"于2018年8月24日就诊。患儿1年前体检时发现左眼视力低下,戴镜后无明显提高,家长未予重视,后左眼症状逐渐加重,到院就诊。
右眼视力(Vod):0.3,-2.00 DS→1.0;左眼视力(Vos):0.04,+1.5 DS/+1.75 DC×75°→0.1;右眼眼压(Iod):10 mmHg(1 mmHg=0.133 kPa);左眼眼压(Ios):11 mmHg。右眼第一眼位正,左眼向外偏斜15°,双眼眼前节及右眼眼底无殊,左眼视网膜大量黄白色渗出,鼻下方视网膜球形隆起。
完善左眼荧光素血管造影(FFA):局灶视网膜毛细血管扩张、多发粟粒状动脉瘤及大片毛细血管无灌注区;左眼光学相干断层扫描(OCT):玻璃体及视网膜外层可见高反射团,黄斑区神经上皮层脱离。结合病史及体征,考虑诊断"左眼Coats病"。
2018年8月24日行左眼全视网膜激光光凝术,2018年11月27行左眼视网膜下液外引流联合冷凝联合玻璃体腔穿刺注药(康柏西普、曲安奈德),术后9个月患儿左眼眼底出现严重的增殖性病变,2019年9月27日行左眼玻璃体切除联合增殖膜剥除联合激光联合硅油注入,2020年3月30日行左眼硅油取出。
硅油取出术后,2020年8月17日前,患者左眼最佳矫正视力(BCVA)为0.6;截至2021年10月18日,患儿左眼BCVA保持0.1。眼压持续随访均在正常范围内。
眼科;儿科
版权归中华医学会所有。本文为遵循CC-BY-NC-ND协议的开放获取文章。
Coats病(Coats disease)又称外层渗出性视网膜病变,由George Coats于1908年首次描述,好发于健康男童,以视网膜血管异常扩张及视网膜外层渗出为特征,大量的视网膜渗出导致的渗出性视网膜脱离是视力预后差的主要影响因素。该病95%以上为单眼发病,表现为散发性及非遗传性,婴幼儿患者常在家长发现斜视、"白瞳"或体检时发现单眼视力低下而就诊,就诊时常常已处于疾病晚期。目前对该病的治疗选择尚存在争议,我们报道1例患儿接受手术治疗后获得良好稳定视力预后的Coats病,旨在提高对本病的认识,为临床治疗提供参考。
患儿男性,11岁,因"体检发现左眼视力低下1年"于2018年8月24日就诊。
患儿1年前体检时发现左眼视力低下,无伴其他不适,家长带至眼镜店配镜后左眼视力仍无明显提高,未至医院就诊或自行处理,后患儿左眼症状逐渐加重,到我院就诊。否认家族中类似病史,否认手术史及外伤史,足月顺产出生,否认出生时吸氧史,母亲怀孕时无殊。
2018年8月24日首次就诊:Vod:0.3,-2.00 DS→1.0;Vos:0.04,+1.5 DS/+1.75 DC×75°→0.1;Iod:10 mmHg(1 mmHg=0.133 kPa);Ios:11 mmHg。
裂隙灯检查:双眼眼前节及右眼眼底检查未见明显异常,左眼眼部检查见大量黄白色渗出及点片状出血,颞侧可见视网膜下增殖膜,鼻下方见局部视网膜球形隆起(图1)。


FFA检查:局灶视网膜毛细血管扩张、多发粟粒状动脉瘤及大片毛细血管无灌注区(图2)。


OCT检查:玻璃体及视网膜外层可见高反射团,黄斑区神经上皮层脱离(图3)。


B超:局部渗出性视网膜脱离。
初步诊断:左眼Coats病,左眼知觉性外斜视,双眼屈光不正。
诊断依据:患儿男性,11岁,单眼慢性发病,Vod:0.3,-2.00 DS→1.0;Vos:0.04,+1.5 DS/+1.75 DC×75°→0.1,左眼向外偏斜15°,眼底见大量黄白色渗出,局部渗出性视网膜脱离,累及黄斑区,FFA示视网膜毛细血管扩张、多发粟粒状动脉瘤及大片毛细血管无灌注区。
鉴别诊断:(1)视网膜母细胞瘤(retinal blastoma,RB):支持点:儿童患者,单眼发病,眼底视网膜向玻璃体腔隆起;不支持点:RB向内生长时呈结节状,浆液性视网膜脱离区域无正常的视网膜血管走行,其他区域亦无Coats病的视网膜血管异常等特征,玻璃体内可见白色肿瘤种子,与本病特征不符;结论:排除RB可能。
(2)早产儿视网膜病变(retinopathy of premature, ROP):支持点:儿童患者,眼底视网膜隆起,大量黄白色渗出;不支持点:本病例患儿为足月顺产出生,否认出生吸氧史,单眼发病;结论:排除ROP可能。
于2018年8月24日,除患儿鼻下方渗出性视网膜脱离区域,余视网膜予视网膜激光光凝治疗。
2018年11月26日:患儿左眼视网膜激光光凝术后首次回院复查,体检:右眼同前;Vos:0.04,+1.5 DS/+1.50 DC×75°→0.1,Ios:10 mmHg,左眼眼底未见明显改善,鼻下视网膜球形隆起基本同前(图4、图5),遂予左眼第一次外科手术:视网膜下液外引流联合冷凝联合玻璃体腔穿刺注药(曲安奈德、康柏西普)。




2018年12月7日:第1次外科术后10 d复查,Vos:0.02,矫正无提高,Ios:11 mmHg,左眼眼底原鼻下渗出性视网膜脱离区域基本平伏。嘱定期复查。(图6、图7)




2019年8月30日:患儿第1次外科手术后8个月回院复查,诉近1个月来左眼视力明显变差,体检:Vos:HM/30 cm,Ios:16 mmHg;左眼周边视网膜可见大量视网膜前增殖膜,鼻下原渗出性视网膜脱离区域可见致密纤维膜覆盖(图8、图9)。




2019年9月27日:施行左眼第2次外科手术:玻璃体切除联合增殖膜剥除联合激光联合硅油植入联合玻璃体腔注药(曲安奈德)。
2019年9月30日:左眼第2次术后3 d复查,体检:Vos:HM/20 cm,矫正无提高,Ios:18 mmHg,左眼玻璃体腔充满硅油,眼底视网膜平伏,视网膜前增殖膜基本清除(图10、图11)。




2020年3月30日:行左眼硅油取出术。后数次复查,左眼BCVA从0.3逐渐提高至0.6,眼压正常(图12)。


2020年8月30日:左眼硅油取出术后5个月复查,体检:Vos 0.3,+2.00 DC×175°→0.6,Ios:12 mmHg,眼底玻璃体腔液体基本透明,周边视网膜见瘢痕灶及视网膜下增殖膜,后极部视网膜清晰平伏(图13、图14)。




2021年7月29日:左眼硅油取出术后1年余复查(患者期间未保持随访),体检:Vos 0.05,+2.00 DC×175°→0.1,Ios:14 mmHg。
Coats病因其特征性的眼底改变,诊断并不难,但由于其起病隐匿,患者就诊时常已处于疾病的晚期,这给临床的治疗选择带来一定的挑战。目前针对Coats病的治疗没有明确有效的方案,一般认为Coats病的治疗因疾病阶段而不同。根据Shields等[1]对Coats病的分期,只有视网膜毛细血管扩张表现的1期患者或伴有渗出但视力未受影响的2期患者,可定期观察;2~3A期的患者可予激光或冷冻治疗;针对已经发生渗出性视网膜脱离的3A期及以上患者,手术为首选;对于4期及5期的患者,若患者无不适,可仅随访观察,若有剧烈眼痛等不适的患者可行眼球摘除术。近年来随着临床对Coats病认识的加深,抗血管内皮生长因子(VEGF)药物也开始应用于Coats病患者中,并取得了看似不错的效果[2,3]。
本病例中患儿就诊时11岁,左眼处于疾病的3A2期(合并局部渗出性视网膜脱离且视网膜脱离累及黄斑中心凹),行视网膜激光光凝术后3个月复查,眼底无明显改善,渗出性视网膜脱离区域同光凝前。视网膜激光光凝被认为可通过直接光凝病变血管以阻止渗漏,早期应用效果较好[4],也有学者认为在伴有渗出性视网膜脱离时,激光光凝有助于使视网膜复位、视力提高[5],但在本案例中未能体现。
患儿随后接受视网膜下液外引流联合冷凝联合玻璃体腔穿刺注药(曲安奈德、康柏西普)术,但在9个月后,眼底发生了严重的增殖性病变,大量致密的纤维增殖膜牵拉视网膜隆起,患儿视力明显下降。冷凝的原理是利用低温将异常毛细血管破坏,减少或阻止渗出,从而使病灶消退,主要用于伴有广泛渗出和视网膜脱离的周围毛细血管扩张症患者,常用于重症病例[6],因为它能有效封闭、复位视网膜。但据报道,冷凝增加了玻璃体视网膜牵引的发生率[7],尤其是冷凝联合抗VEGF药物使用时,发生牵拉性视网膜脱离的风险大大升高[8]。尽管抗VEGF药物被证实可以显著减少黄斑水肿及视网膜渗出,改善视力[2],但也有多项研究认为抗VEGF药物可能与玻璃体视网膜纤维增殖以及随后的牵拉性视网膜脱离有关[9,10,11],尤其当与冷凝联合使用时,这种导致玻璃体视网膜严重增殖的效应将被放大,提醒我们临床上可能需谨慎联合使用冷凝及抗VEGF药物治疗。
积极的治疗干预后发生严重的增殖性玻璃体视网膜病变无疑令人气馁,但玻璃体切除术作为治疗复杂眼底病变的最终方法,在年轻的患者身上仍值得一试。在本案例中,玻璃体切除术后的短期效果令人欣喜,患者在随后近一年的随访中,术眼视力均保持在0.5以上,眼压正常。然而不得不提的是,Coats病作为一种慢性病,尽管已经进行了诸多治疗干预并在短期内获得了不错的效果,我们仍应意识到长期密切随访的重要性,以及时采取相应治疗措施,延缓或制止疾病的进展。该病例中,患儿在玻璃体切除术后未能保持定期随访,最后一次复查的最佳矫正视力也反映出Coats病可能仍在缓慢进展中,也从侧面说明Coats病的长期预后不佳,但无可否认的是积极的手术治疗仍取得了较好的效果。
Coats病的自然病程最终会进展为失明甚至眼球萎缩,且发病年龄越小,疾病进展越快,预后越差,因此,当确诊Coats病时,应积极地采取措施进行治疗。目前对Coats病的发病机制认识不全面,对Coats病的治疗选择仍存在争议,从本病例看,我们认为冷凝联合抗VEGF药物注射治疗的方案可能会导致较严重的增殖性玻璃体视网膜病变,玻璃体切除术是治疗复杂眼底病变的有效手段,Coats病的患者大多较年轻,及时发现疾病、积极地治疗干预对患者的视力预后至关重要。
所有作者均声明本研究不存在利益冲突